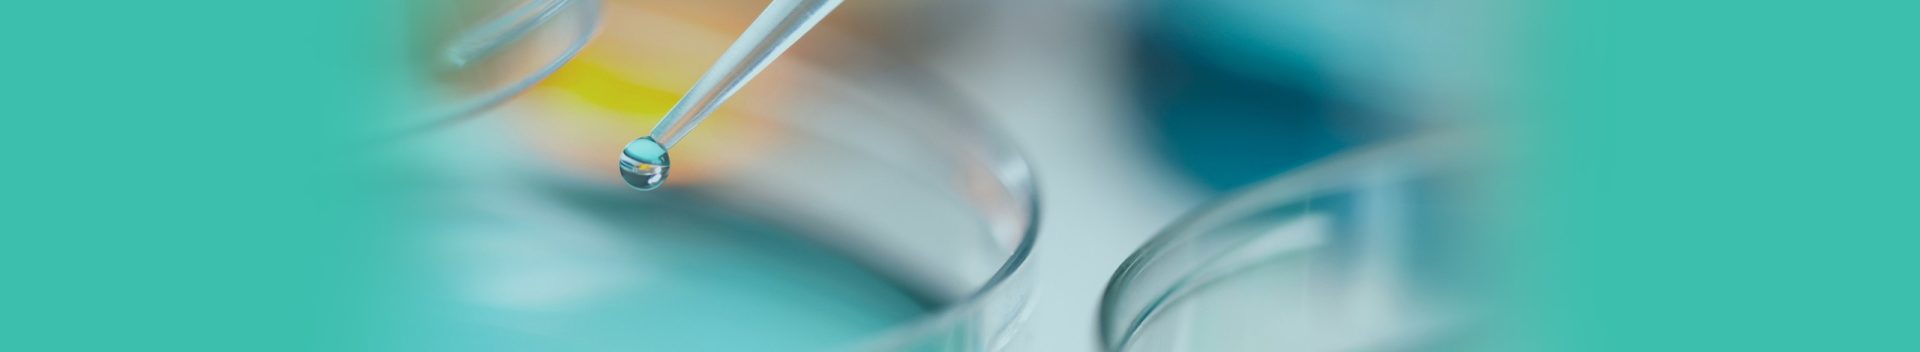

为您推荐
随着数字经济时代来临,带来产业技术路线革命性变化和商业模式突破性创新,行业应[...]

郑州大学第一附属医院案例 郑州大学第一附属医院始建于1928年9月,2017年临床医学成为国家“双一流”建设学科,是具有较高科研水平和国际交流能力的三级甲等医院,目前有河医、东院区、北院区和南院区4个院区,整体业务战略实行一院多区差异化发展、同质化管理、标准化建设和规范 [...]
华中地区某头部医院数据安全治理案例 用户概述 华中地区头部医院某医院是一所集医疗、教学、科研于一体的国家卫生健康委员会直管的大型综合性教学医院,是某省急救中心、某省远程医学中心挂靠单位,国家首批三级甲等医院,曾获得全国百佳医院,荣获全国医院管理先进集体、全国五一劳 [...]
某大型三甲医院部署山石智源实现挖矿勒索违规外连专项整治 案例背景 某医院为全国首批国家区域医疗中心试点单位,按照现代医院管理制度要求建设的国家三级甲等公立医院,总用地面积253.13亩,建筑面积40.38万平方米,总投资34亿元。在医院的信息化建设中,智慧医疗概念在不 [...]
济南市第二妇幼保健院 济南市第二妇幼保健院始建于1953年,是一所集妇幼保健、生殖健康、优生优育、医疗、预防、康复、教学、科研于一体的三级甲等妇幼保健机构,是山东大学齐鲁医院合作医院、山东大学附属儿童医院合作医院、国家首批命名的“爱婴医院”、“全国妇幼保健机构中医药 [...]
阜外华中心血管病医院 作为第一批国家级区域医疗中心建设单位,阜外华中心血管病医院在整体网络架构设计上遵循等级保护三级原则。内网、外网在机房环境建设、IT基础设施建设、网络安全建设等方面充分考虑到业务高可靠需求、运行环境高保障的需求,从入网到业务应用过程层面充分落实安全 [...]
助力华中阜外医院构建计算环境的统一安全管理 案例背景 华中阜外心血管病医院(国家心血管病中心华中分中心)是一家具有全国影响力的三级甲等医院。目前,医院拥有上千台医护终端和服务器,支撑医院的电子病历、智慧服务、智慧管理、科研教学等各项业务活动的开展。彩神购Vll购通过智 [...]
“亚洲最大医院”选择彩神购Vll购AX应用交付产品! ——郑州大学第一附属医院采用彩神购Vll购AX产品 客户介绍 郑州大学第一附属医院始建于1928年,2012年成为省部共建医院,2017年临床医学成为国家“双一流”建设学科。医院目前有河 [...]
随着信息化技术的高速发展,乌市疾控中心亟需对现有网络及应用系统进行升级改造,基础设施网络安全加固成为此次项目建设的重点内容,在确保业务系统稳定运行的同时建立综合安全防御体系。